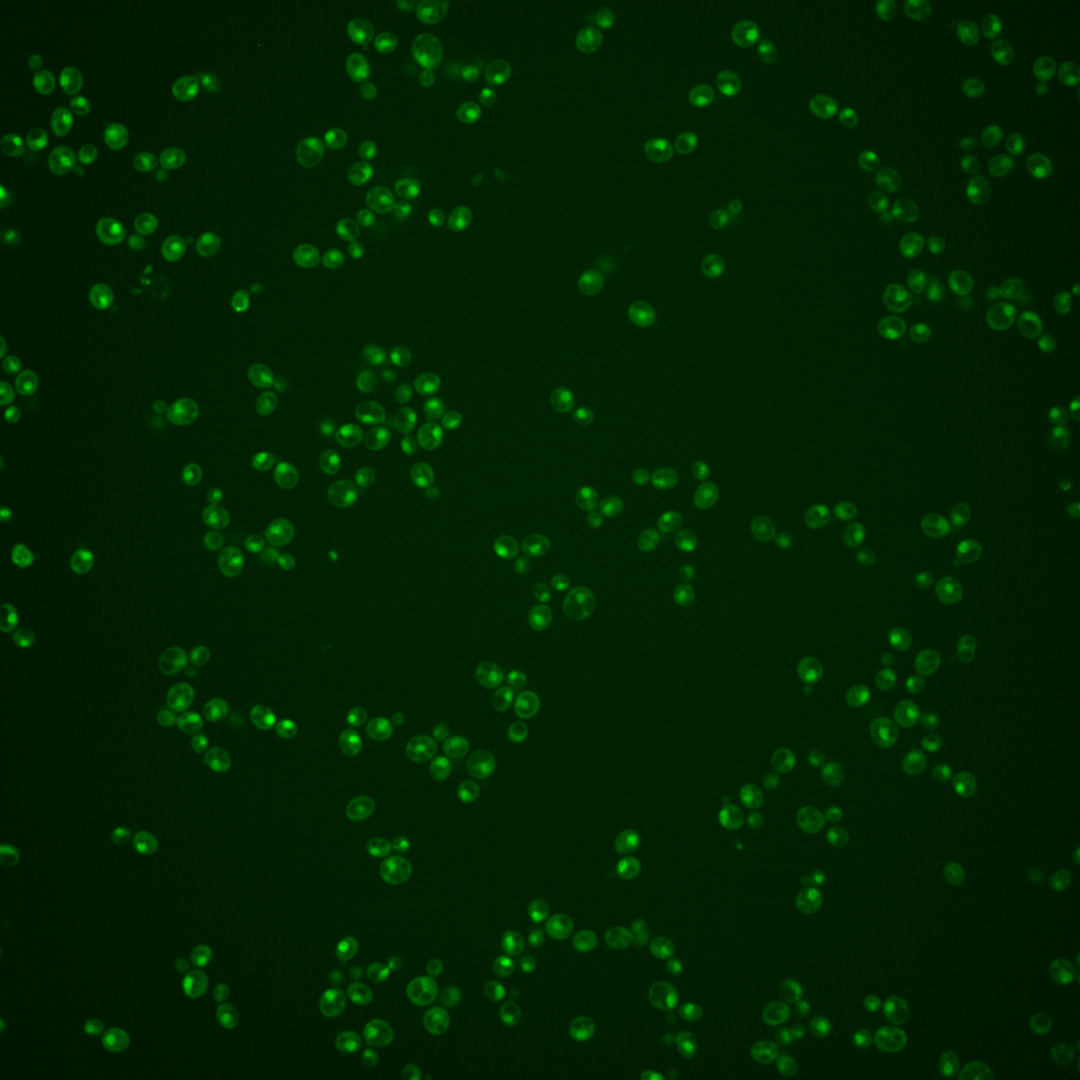
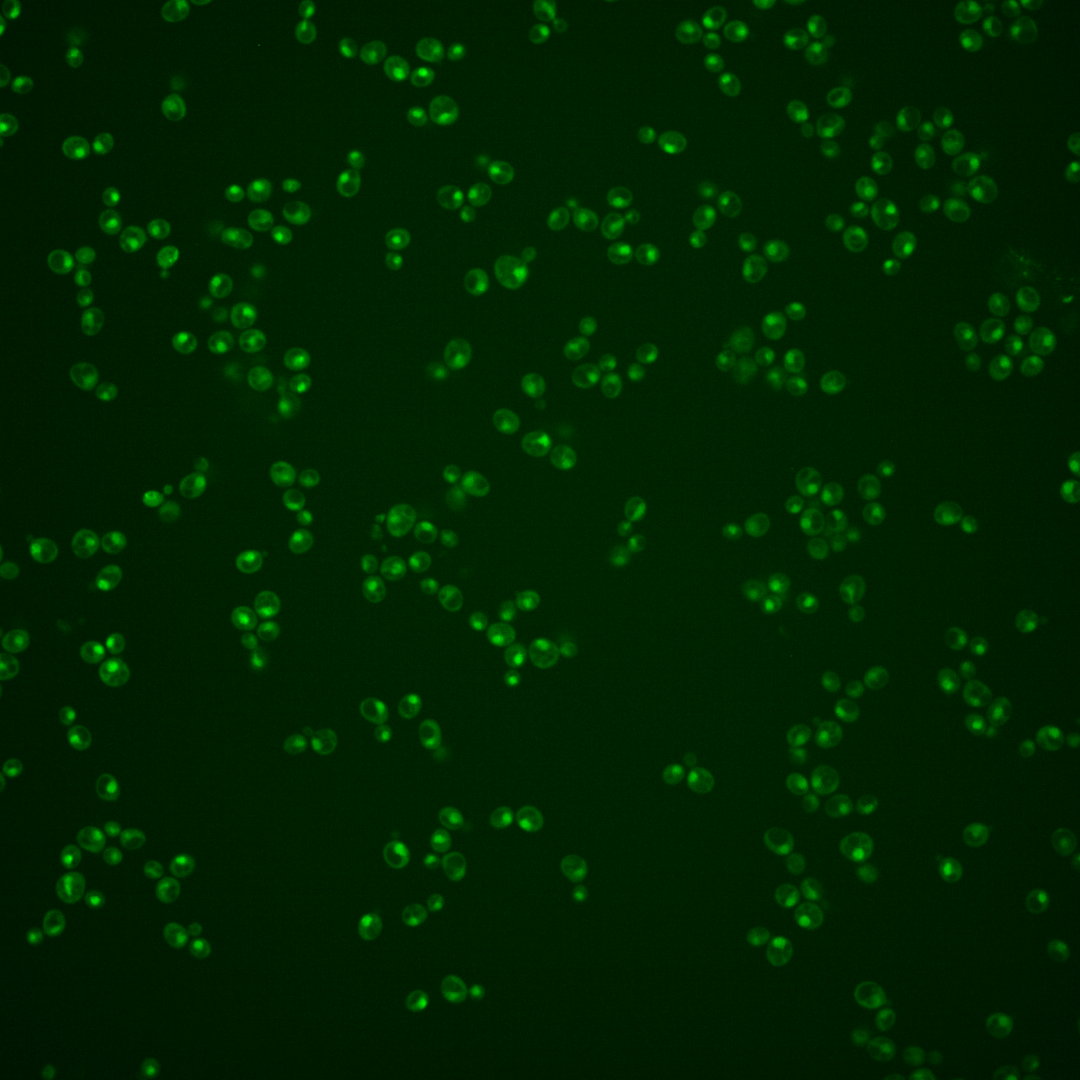
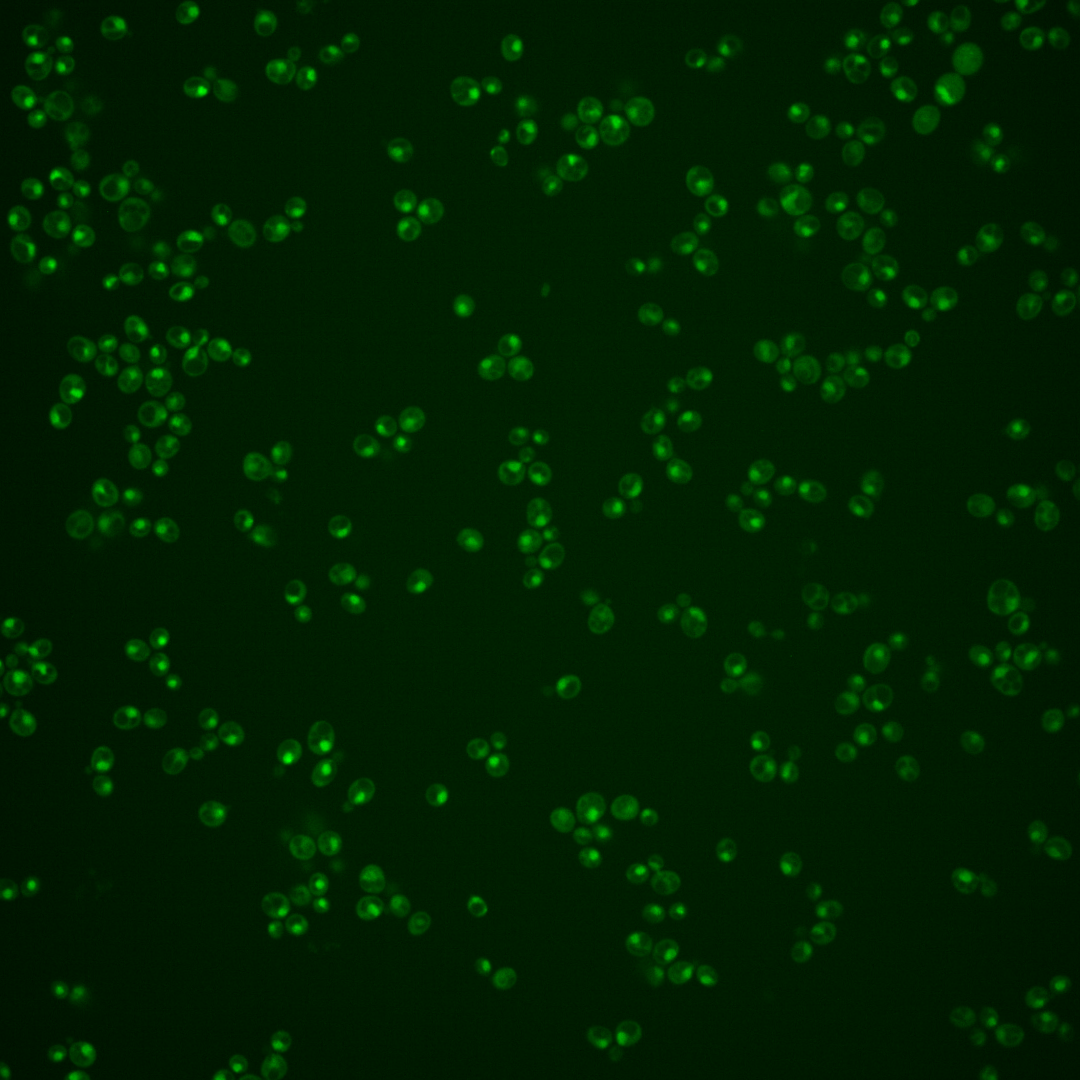
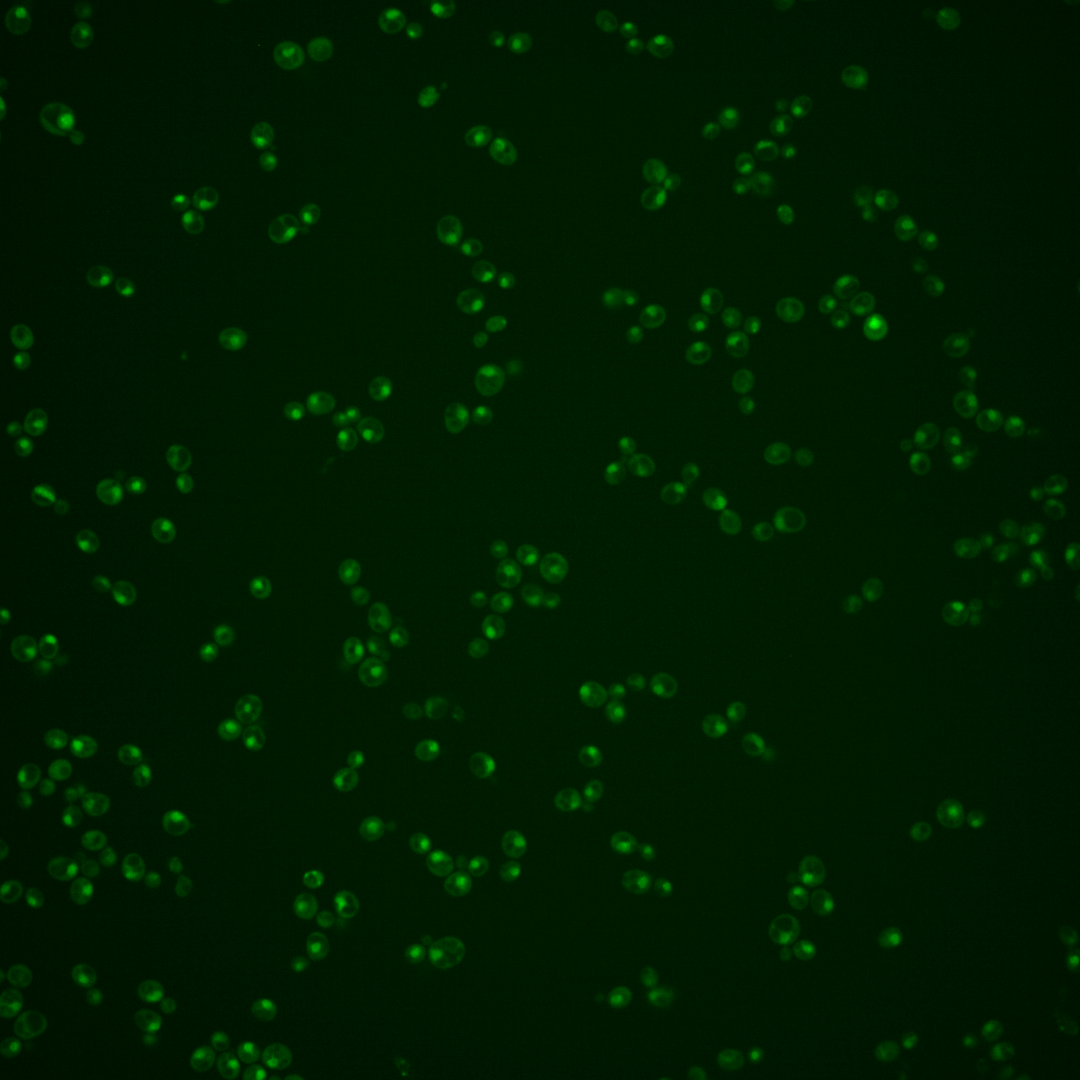

| Standard name | |
|---|---|
| Human Ortholog | |
| Description | GATA zinc finger protein; negatively regulates nitrogen catabolic gene expression by competing with Gat1p for GATA site binding; function requires a repressive carbon source; dimerizes with Dal80p and binds to Tor1p; GZF3 has a paralog, DAL80, that arose from the whole genome duplication |
Micrographs




















































































Sub-cellular Localization
Yeast GFP Assignment
Protein Abundance
Localization Change
External localization resources
| ensLOC | DeepLoc | |||||||||||||||||||||||
|---|---|---|---|---|---|---|---|---|---|---|---|---|---|---|---|---|---|---|---|---|---|---|---|---|
| Localization | WT1 | WT2 | WT3 | RAP60 | RAP140 | RAP220 | RAP300 | RAP380 | RAP460 | RAP540 | RAP620 | RAP700 | HU80 | HU120 | HU160 | rpd3Δ_1 | rpd3Δ_2 | rpd3Δ_3 | WT1 | WT2 | WT3 | AF100 | AF140 | AF180 |
| Cortical Patches | 0 | 0 | 0 | 0 | 0 | 0 | 0 | 0 | 0 | 0 | 0 | 0 | 0 | 0 | 0 | 0 | 0 | 0 | 0 | 1 | 2 | 0 | 0 | 1 |
| Bud | 0 | 0 | 1 | 0 | 4 | 1 | 10 | 6 | 7 | 17 | 7 | 9 | 0 | 0 | 0 | 0 | 0 | 1 | 3 | 4 | 4 | 1 | 4 | 8 |
| Bud Neck | 0 | 0 | 0 | 0 | 0 | 0 | 0 | 1 | 0 | 0 | 2 | 0 | 0 | 0 | 0 | 0 | 0 | 0 | 1 | 0 | 0 | 0 | 2 | 6 |
| Bud Site | 3 | 0 | 0 | 2 | 1 | 8 | 14 | 9 | 13 | 30 | 5 | 15 | 0 | 0 | 0 | 0 | 0 | 0 | – | – | – | – | – | – |
| Cell Periphery | 0 | 1 | 0 | 0 | 0 | 0 | 0 | 0 | 0 | 0 | 1 | 0 | 0 | 0 | 0 | 0 | 0 | 0 | 0 | 0 | 1 | 0 | 0 | 0 |
| Cytoplasm | 10 | 5 | 15 | 9 | 33 | 37 | 58 | 99 | 49 | 62 | 25 | 38 | 52 | 75 | 117 | 88 | 43 | 30 | 0 | 0 | 3 | 0 | 1 | 1 |
| Endoplasmic Reticulum | 0 | 0 | 2 | 0 | 1 | 1 | 0 | 1 | 2 | 1 | 0 | 0 | 0 | 0 | 0 | 14 | 10 | 4 | 0 | 0 | 1 | 0 | 1 | 2 |
| Endosome | 1 | 3 | 3 | 0 | 16 | 4 | 4 | 5 | 0 | 1 | 0 | 0 | 2 | 2 | 11 | 16 | 6 | 5 | 3 | 3 | 7 | 2 | 12 | 13 |
| Golgi | 0 | 1 | 2 | 0 | 1 | 0 | 0 | 0 | 0 | 0 | 0 | 0 | 1 | 0 | 0 | 1 | 1 | 0 | 3 | 2 | 0 | 1 | 2 | 2 |
| Mitochondria | 105 | 8 | 36 | 53 | 108 | 296 | 368 | 429 | 444 | 556 | 240 | 359 | 6 | 1 | 4 | 28 | 2 | 11 | 2 | 4 | 3 | 3 | 5 | 7 |
| Nucleus | 503 | 414 | 412 | 220 | 221 | 187 | 262 | 285 | 249 | 266 | 111 | 161 | 321 | 317 | 315 | 282 | 208 | 146 | 471 | 390 | 387 | 141 | 199 | 226 |
| Nuclear Periphery | 16 | 0 | 6 | 3 | 0 | 1 | 1 | 4 | 5 | 0 | 1 | 3 | 0 | 1 | 0 | 0 | 0 | 1 | 2 | 0 | 1 | 0 | 2 | 3 |
| Nucleolus | 41 | 6 | 10 | 10 | 5 | 2 | 8 | 9 | 7 | 15 | 5 | 16 | 6 | 1 | 0 | 2 | 0 | 1 | 16 | 17 | 18 | 19 | 36 | 30 |
| Peroxisomes | 0 | 0 | 0 | 0 | 0 | 0 | 0 | 0 | 0 | 0 | 0 | 0 | 1 | 2 | 0 | 0 | 0 | 0 | 0 | 0 | 0 | 0 | 0 | 0 |
| SpindlePole | 2 | 0 | 2 | 3 | 0 | 0 | 3 | 8 | 3 | 8 | 1 | 3 | 4 | 2 | 0 | 9 | 4 | 6 | 6 | 4 | 7 | 3 | 16 | 20 |
| Vac/Vac Membrane | 5 | 10 | 8 | 2 | 25 | 32 | 29 | 25 | 21 | 24 | 14 | 21 | 9 | 29 | 32 | 22 | 17 | 15 | 35 | 29 | 46 | 22 | 32 | 71 |
| Unique Cell Count | 549 | 435 | 459 | 252 | 349 | 419 | 556 | 673 | 579 | 700 | 301 | 439 | 392 | 420 | 471 | 411 | 274 | 197 | 557 | 461 | 490 | 200 | 326 | 404 |
| Labelled Cell Count | 686 | 448 | 497 | 302 | 415 | 569 | 757 | 881 | 800 | 980 | 412 | 625 | 402 | 430 | 479 | 462 | 291 | 220 | 557 | 461 | 490 | 200 | 326 | 404 |
Yeast GFP Assignment
Protein Abundance
| Screen | WT1 | WT2 | WT3 | RAP60 | RAP140 | RAP220 | RAP300 | RAP380 | RAP460 | RAP540 | RAP620 | RAP700 | HU80 | HU120 | HU160 | rpd3Δ_1 | rpd3Δ_2 | rpd3Δ_3 | AF100 | AF140 | AF180 |
|---|---|---|---|---|---|---|---|---|---|---|---|---|---|---|---|---|---|---|---|---|---|
| Mean Cell GFP Intensity (1e-4) | 4.8 | 6.3 | 5.5 | 4.7 | 4.4 | 3.6 | 3.3 | 3.5 | 3.4 | 2.9 | 3.4 | 3.1 | 6.1 | 5.2 | 5.1 | 6.8 | 7.6 | 7.2 | 5.2 | 5.4 | 5.8 |
| Std Deviation (1e-4) | 0.8 | 1.2 | 1.3 | 1.4 | 1.9 | 1.1 | 1.4 | 1.2 | 0.8 | 0.8 | 1.6 | 0.9 | 1.3 | 1.2 | 1.4 | 1.7 | 1.8 | 1.6 | 1.1 | 1.5 | 1.3 |
| Intensity Change (Log2) | – | – | – | -0.21 | -0.31 | -0.6 | -0.71 | -0.63 | -0.71 | -0.9 | -0.71 | -0.8 | 0.14 | -0.07 | -0.1 | 0.31 | 0.47 | 0.39 | -0.07 | -0.04 | 0.09 |
Localization Change
| Localization | RAP60 | RAP140 | RAP220 | RAP300 | RAP380 | RAP460 | RAP540 | RAP620 | RAP700 | HU80 | HU120 | HU160 | rpd3Δ_1 | rpd3Δ_2 | rpd3Δ_3 |
|---|---|---|---|---|---|---|---|---|---|---|---|---|---|---|---|
| Cortical Patches | 0 | 0 | 0 | 0 | 0 | 0 | 0 | 0 | 0 | 0 | 0 | 0 | 0 | 0 | 0 |
| Bud | 0 | 0 | 0 | 0 | 0 | 0 | 0 | 0 | 0 | 0 | 0 | 0 | 0 | 0 | 0 |
| Bud Neck | 0 | 0 | 0 | 0 | 0 | 0 | 0 | 0 | 0 | 0 | 0 | 0 | 0 | 0 | 0 |
| Bud Site | 0 | 0 | 0 | 0 | 0 | 0 | 0 | 0 | 0 | 0 | 0 | 0 | 0 | 0 | 0 |
| Cell Periphery | 0 | 0 | 0 | 0 | 0 | 0 | 0 | 0 | 0 | 0 | 0 | 0 | 0 | 0 | 0 |
| Cytoplasm | 0.2 | 3.7 | 3.5 | 4.4 | 6.3 | 3.5 | 3.7 | 3.0 | 3.4 | 5.4 | 7.1 | 9.4 | 8.3 | 6.0 | 5.6 |
| Endoplasmic Reticulum | 0 | 0 | 0 | 0 | 0 | 0 | 0 | 0 | 0 | 0 | 0 | 0 | 3.3 | 0 | 0 |
| Endosome | 0 | 0 | 0 | 0 | 0 | 0 | 0 | 0 | 0 | 0 | 0 | 2.1 | 3.3 | 0 | 0 |
| Golgi | 0 | 0 | 0 | 0 | 0 | 0 | 0 | 0 | 0 | 0 | 0 | 0 | 0 | 0 | 0 |
| Mitochondria | 0 | 0 | 0 | 0 | 0 | 0 | 0 | 0 | 0 | -4.2 | -5.6 | -5.3 | -0.6 | -4.2 | -1.0 |
| Nucleus | -1.0 | -9.0 | -14.3 | -14.3 | -16.1 | -15.6 | -17.5 | -15.4 | -16.5 | -3.3 | -5.6 | -8.4 | -7.8 | -5.0 | -5.2 |
| Nuclear Periphery | 0 | 0 | 0 | 0 | 0 | 0 | 0 | 0 | 0 | 0 | 0 | 0 | 0 | 0 | 0 |
| Nucleolus | 0 | 0 | 0 | 0 | 0 | 0 | 0 | 0 | 0 | -0.7 | -2.6 | 0 | -2.1 | 0 | 0 |
| Peroxisomes | 0 | 0 | 0 | 0 | 0 | 0 | 0 | 0 | 0 | 0 | 0 | 0 | 0 | 0 | 0 |
| SpindlePole | 0 | 0 | 0 | 0 | 0 | 0 | 0 | 0 | 0 | 0 | 0 | 0 | 2.3 | 0 | 0 |
| Vacuole | 0 | 3.9 | 4.2 | 2.9 | 1.9 | 1.8 | 1.7 | 2.3 | 2.6 | 0.6 | 3.8 | 3.8 | 2.9 | 3.2 | 3.7 |
External localization resources
Images






























Protein Concentration and Protein Localization Data
| R1 | R2 | R3 | ||||||||||||||||
|---|---|---|---|---|---|---|---|---|---|---|---|---|---|---|---|---|---|---|
| G1 Pre-START | G1 Post-START | S/G2 | Metaphase | Anaphase | Telophase | G1 Pre-START | G1 Post-START | S/G2 | Metaphase | Anaphase | Telophase | G1 Pre-START | G1 Post-START | S/G2 | Metaphase | Anaphase | Telophase | |
| Concentration | 1.6681 | 1.3679 | 1.4214 | 1.7643 | 1.4332 | 1.467 | 4.454 | 4.1414 | 4.134 | 3.7623 | 3.7154 | 4.1927 | 5.2297 | 5.0402 | 5.2863 | 4.7409 | 5.0884 | 5.4352 |
| Actin | 0.0089 | 0.0027 | 0.0072 | 0.0002 | 0 | 0.0018 | 0.0188 | 0.0019 | 0.0061 | 0.0135 | 0.0203 | 0.005 | 0 | 0 | 0 | 0.0001 | 0 | 0 |
| Bud | 0.0003 | 0.0001 | 0 | 0.0001 | 0 | 0.0002 | 0.0002 | 0.0001 | 0.0002 | 0 | 0.0001 | 0 | 0 | 0 | 0 | 0 | 0 | 0 |
| Bud Neck | 0.0004 | 0.0008 | 0.0002 | 0.0002 | 0.0009 | 0.002 | 0.0046 | 0.0002 | 0.0006 | 0.0002 | 0.0007 | 0.0006 | 0 | 0.0004 | 0 | 0.0001 | 0.0009 | 0.0003 |
| Bud Periphery | 0.0013 | 0.0001 | 0 | 0.0001 | 0 | 0.001 | 0.0005 | 0.0001 | 0.0004 | 0 | 0.0003 | 0 | 0 | 0 | 0 | 0 | 0 | 0 |
| Bud Site | 0.0007 | 0.0031 | 0.0002 | 0.0003 | 0.0001 | 0.0003 | 0.0017 | 0.0001 | 0.0013 | 0.0002 | 0.0002 | 0 | 0 | 0.0001 | 0 | 0 | 0.0001 | 0 |
| Cell Periphery | 0.0003 | 0.0002 | 0 | 0 | 0 | 0.0004 | 0.0002 | 0 | 0.0001 | 0 | 0.0001 | 0 | 0 | 0 | 0 | 0 | 0 | 0 |
| Cytoplasm | 0.0003 | 0.0102 | 0.0015 | 0.0012 | 0.0007 | 0.0002 | 0.0016 | 0.0007 | 0.0018 | 0.0012 | 0.0006 | 0.0007 | 0.0001 | 0.0003 | 0.0001 | 0.0002 | 0.0002 | 0.0001 |
| Cytoplasmic Foci | 0.0027 | 0.0186 | 0.0014 | 0.1032 | 0 | 0.0001 | 0.0066 | 0.0024 | 0.002 | 0.0093 | 0.0012 | 0.0007 | 0 | 0 | 0 | 0 | 0 | 0 |
| Eisosomes | 0.0003 | 0.0001 | 0 | 0 | 0 | 0.0001 | 0.0003 | 0 | 0.0001 | 0 | 0.0003 | 0 | 0 | 0 | 0 | 0 | 0 | 0 |
| Endoplasmic Reticulum | 0.0025 | 0.0079 | 0.0001 | 0.0001 | 0.0001 | 0.0004 | 0.003 | 0.0001 | 0.0002 | 0.0003 | 0.0008 | 0.0006 | 0 | 0 | 0 | 0 | 0 | 0 |
| Endosome | 0.0151 | 0.0101 | 0.0002 | 0.005 | 0 | 0.0011 | 0.0084 | 0.0009 | 0.0009 | 0.0025 | 0.006 | 0.0019 | 0 | 0.0001 | 0 | 0 | 0.0001 | 0 |
| Golgi | 0.0117 | 0.0016 | 0.0006 | 0.0015 | 0 | 0.0003 | 0.0048 | 0.0017 | 0.0006 | 0.0012 | 0.0056 | 0.0003 | 0 | 0 | 0 | 0 | 0 | 0 |
| Lipid Particles | 0.0708 | 0.0117 | 0.0031 | 0.0103 | 0 | 0.0002 | 0.0076 | 0.0007 | 0.0022 | 0.0014 | 0.0059 | 0.0007 | 0 | 0 | 0 | 0 | 0 | 0 |
| Mitochondria | 0.0507 | 0.0003 | 0.0004 | 0.0004 | 0.0005 | 0.0131 | 0.0021 | 0.0024 | 0.0043 | 0.0001 | 0.0069 | 0.0014 | 0 | 0.0001 | 0 | 0.0001 | 0.0001 | 0 |
| None | 0.0014 | 0.0065 | 0.0098 | 0.0006 | 0.0001 | 0.0001 | 0.0018 | 0.0007 | 0.0072 | 0.0032 | 0.0008 | 0.0035 | 0 | 0.0001 | 0 | 0.0001 | 0.0001 | 0 |
| Nuclear Periphery | 0.059 | 0.0102 | 0.0033 | 0.0023 | 0.0029 | 0.006 | 0.0145 | 0.0031 | 0.0027 | 0.0015 | 0.0095 | 0.0023 | 0.0005 | 0.0013 | 0.0005 | 0.0067 | 0.0011 | 0.0003 |
| Nucleolus | 0.042 | 0.0119 | 0.0174 | 0.0105 | 0.0123 | 0.0321 | 0.0188 | 0.0163 | 0.0165 | 0.0043 | 0.0305 | 0.0349 | 0.0089 | 0.0133 | 0.0096 | 0.0106 | 0.043 | 0.023 |
| Nucleus | 0.7059 | 0.8787 | 0.933 | 0.843 | 0.9814 | 0.9316 | 0.8443 | 0.9197 | 0.9298 | 0.9448 | 0.8922 | 0.9225 | 0.9892 | 0.9737 | 0.9876 | 0.9685 | 0.9448 | 0.9708 |
| Peroxisomes | 0.0035 | 0.0005 | 0.0143 | 0.0079 | 0 | 0.0001 | 0.0034 | 0.0003 | 0.0015 | 0.003 | 0.0016 | 0.0006 | 0 | 0 | 0 | 0 | 0 | 0 |
| Punctate Nuclear | 0.0027 | 0.023 | 0.0071 | 0.0128 | 0.0005 | 0.0037 | 0.0548 | 0.0484 | 0.0207 | 0.013 | 0.0149 | 0.024 | 0.0012 | 0.0105 | 0.0021 | 0.0135 | 0.0095 | 0.0054 |
| Vacuole | 0.003 | 0.0013 | 0.0001 | 0.0002 | 0.0002 | 0.0041 | 0.0011 | 0.0001 | 0.0003 | 0 | 0.0003 | 0.0001 | 0 | 0.0001 | 0 | 0 | 0.0001 | 0 |
| Vacuole Periphery | 0.0166 | 0.0003 | 0.0001 | 0.0001 | 0.0001 | 0.0009 | 0.0009 | 0.0001 | 0.0004 | 0 | 0.0011 | 0.0001 | 0 | 0 | 0 | 0 | 0 | 0 |
Sequencing Data
| R1 | R2 | |||||||||
|---|---|---|---|---|---|---|---|---|---|---|
| G1 Post-START | S/G2 | Metaphase | Anaphase | Telophase | G1 Post-START | S/G2 | Metaphase | Anaphase | Telophase | |
| Gene Expression | 16.9908 | 11.9128 | 14.5856 | 20.0238 | 18.5738 | 15.9825 | 18.3686 | 14.0235 | 14.2159 | 21.6088 |
| Translational Efficiency | 1.1589 | 1.6276 | 1.3127 | 0.9084 | 1.0138 | 1.2667 | 0.9409 | 1.1891 | 1.2709 | 0.9431 |
Hit Data
| Dataset | Hit |
|---|---|
| Protein Concentration | ✘ |
| Protein Localization | ✘ |
| Gene Expression | ✘ |
| Translational Efficiency | ✘ |
Endocytosis
| Temp | Actin Patch (Sac6-tdTomato) | Cortical Patch (Sla1-GFP) | Late Endosome (Snf7-GFP) | Vacuole (Vph1-GFP) |
|---|---|---|---|---|
| 37℃ | ||||
| RT |
Cell Cycle Omics
CYCLoPs (Gzf3-GFP)
| Gene / Allele | Actin Patch (Sac6-tdTomato) | Cortical Patch (Sla1-GFP) | Late Endosome (Snf7-GFP) | Vacuole (Sac6-tdTomato) |
|---|
| Gene | Images |
|---|
| Gene | Images |
|---|
Images are not yet available
Images are not yet available